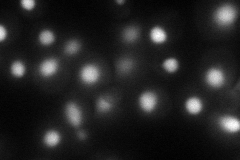
YER029C
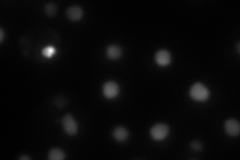
YER029C
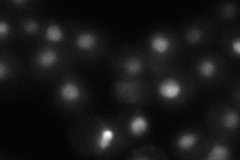
YER029C
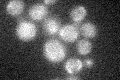
YER029C

View description
Core Sm protein Sm B; part of heteroheptameric complex (with Smd1p, Smd2p, Smd3p, Sme1p, Smx3p, and Smx2p) that is part of the spliceosomal U1, U2, U4, and U5 snRNPs; homolog of human Sm B and Sm B'
Localization:
Intensity:
Fold change:
Significance:
-
C’ GFP library in SD

below threshold19.04 -
N' NOP1pr-GFP in SD
nucleus64.2436 -
N' TEF2pr-mCherry in SD
nucleus50.865 -
N' NATIVEpr-GFP in SD
nucleus38.9174 -
N' TEF2pr-VC and Cyto-VN in SD

nucleus27.7566 -
C’ GFP library in SD+DTT

cytosol13.490.7No -
C’ GFP library in SD+H2O2
cytosol15.850.83No -
C’ GFP library in Starvation Media

cytosol17.090.89No -
C’ GFP library on the background of Pup2-DaMP

below threshold -
C’ GFP library on the background of CCT mutant

below threshold16.71670.87781No
